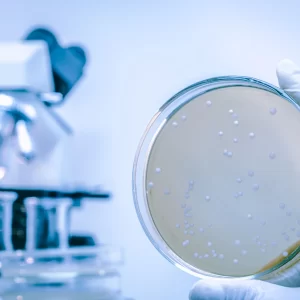
(ES) Online Training: Formación Operaciones Menores en la prevención y control de Legionella en España

Kurita eCommerce
You are one click away from ordering Kurita’s tailored-specific services and products
Available Services & Solutions
Explore Kurita’s service portfolio and smart solutions
About Kurita
Sustainability
Helping industries meet their sustainability goals
Innovation
World Class Services and Solutions
Tailored Solutions
Industry-specific water treatment programs
Expert Support
Our experts supports you every step of the way
Why Buy Kurita Services Online?
Kurita’s online store gives you 24/7 access to tailored solutions, transparent pricing, and instant onboarding – no waiting, no paperwork. Get expert support and exclusive online offers, all in one place.
Sustainability, efficiency, and innovation at your disposal in one click.
Contact Us
If you have any questions or need assistance with your order, please contact us.